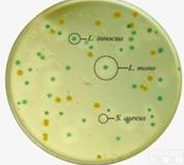
<em>卵黄</em>氯化钠<em>琼脂</em>培养基<em>基础</em> <em>卵黄</em>氯化钠<em>琼脂</em>培养基<em>基础</em>

锰盐营养琼脂,疱肉培养基基础,卵黄琼脂基础
- 产地:上海金穗生物科技有限公司
- 供应商:上海金穗生物科技有限公司
- 供应商报价:面议
- 标签:锰盐营养琼脂,疱肉培养基基础,卵黄琼脂基础,-1,上海金穗生物科技有限公司
| 锰盐营养琼脂 | 250g | 询价 | 用于嗜热需氧芽孢杆菌的检验 |
| Mn2+Nutrient Agar | |||
| 疱肉培养基基础 | 250g | 询价 | 加入牛肉粒,用于肉毒梭菌及厌氧梭状芽孢杆菌的检验 |
| Cooked Meat Medium Base | |||
| 卵黄琼脂基础 | 250g | 询价 | 加入卵黄,用于厌氧梭状芽孢杆菌的分离培养 |
| Egg Yolk Agar Base |
上海金穗生物科技有限公司专业销售各种生化试剂、培养基,标准品、透析袋。各种动物血清,血浆,本公司所有产品主要用于科研方面,不用于临床诊断。洽询!全国免费: